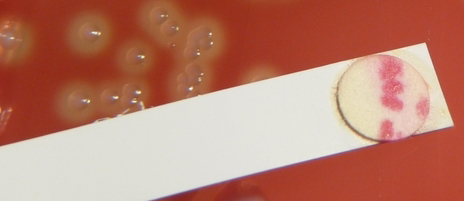

![]()
Created by
Paul A. Gulig, Ph.D.
Department of Molecular Genetics and Microbiology
with assistance from
David Brumbaugh
Here are the results of the PYR and CAMP tests.
For the PYR test, some of the isolated colony type 2 from the blood agar plates was placed on the white PYR test strip. The color change can be seen in the image.
For the CAMP test, a colony was cross-streaked on a blood agar plate that had been streaked with Staphylococcus aureus. The plate was incubated overnight at 37C. The next day, here is what the plate looked like:

What
do these results mean?
A. It is
viridans
Streptococcus
B. It is Streptococcus
pneumoniae
C. It is Streptococcus
pyogenes
D. It is Streptococcus agalactiae
Be sure and look below for the other test results.
Here are the results of the Binax Srep A test.

What
has happened in this test?
A. Positive for
Group
A strep because both the sample and control lines reacted.
B. Negative for
Group
A strep because both the sample and control lines reacted.
C. The test is
uninterpretable.